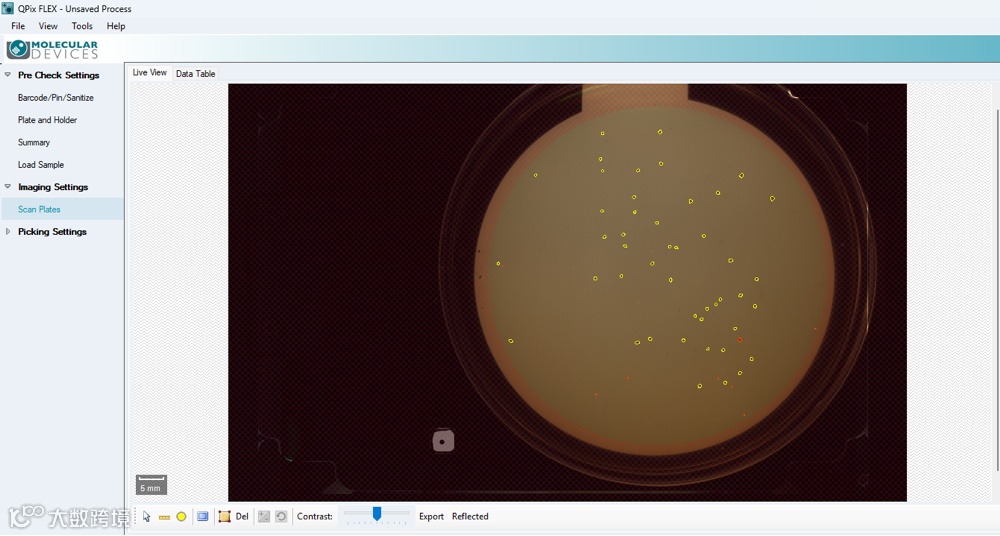

益生菌,作为可以带来健康利益的微生物,不仅受到学术界的关注,也为工业界带来诸多机遇,特别是食品工业及制药产业。从日常饮食中的发酵乳,奶酪,婴儿配方奶粉到临床用于腹泻、炎性肠病等干预治疗,益生菌正发挥越来越广泛的功能[1]。研究表明,益生菌能调节肠道菌群,与病原菌竞争粘膜及表皮的生态位,增强肠道表皮的完整性并且能调节免疫系统[2]。目前常提及的益生菌包括乳酸菌一类的传统益生菌,非乳酸菌类的益生菌包括双歧杆菌、肠球菌、酵母益生菌等以及嗜酸乳杆菌、罗伊氏粘液乳杆菌等乳酸杆菌,青春双歧杆菌、长双歧杆菌、短双歧杆菌等双歧杆菌以及嗜黏蛋白阿克曼氏菌、普氏粪杆菌等下一代益生菌[1]。尽管现有的益生菌已经被广泛应用于食品及保健品加工、临床应用,开发新一代性能更加优越的益生菌的需求依然存在。
此次,我们联合知名益生菌定制化应用企业浙江省宁波市元生生物科技有限公司,利用 Molecular Devices 公司新推出的 QPix FLEX 微生物克隆筛选系统对益生菌筛选过程进行了优化测试。本次测试旨在优化原有的克隆筛选流程,用仪器替代原本大部分的手工操作,同时检验仪器在涂布、移液、克隆挑选及样本复制重排方面的表现。


仪器:QPix FLEX 微生物克隆筛选系统。

样本:益生菌来源样本稀释液,灭菌培养基。

耗材:96 孔深孔板,9cm petri dish 琼脂板,单孔加样槽,QPix FLEX 配套的 50 μl 移液枪头,1000 μl 移液枪头,涂布划线头。

将益生菌来源样本进行预处理后,使用 0.85% 生理盐水进行梯度稀释至 10-6,对稀释后的样本进行涂布,厌氧环境 37℃ 培养,菌落长出后挑克隆至液体培养基中扩培,扩培后的菌液取菌落沉淀,MALDI-TOF-MS 鉴定,选取目标菌液体培养基扩培,用甘油冻存筛选到的益生菌(图 1)。

图 1:QPix FLEX 益生菌筛选流程

01
涂布
QPix FLEX 配备琼脂高度探测器,尽管平板培养基厚薄差异大,经 QPix FLEX 涂布后,菌液被成功涂布到琼脂培养基的各个区域(图 2),微生物成功在琼脂培养基上生长。

图 2:QPix FLEX 涂布操作
02
分装培养基
利用 QPix FLEX 的移液功能,可将 96 孔培养板按体积铺满接种所需的培养基(图 3)。

图 3:QPix FLEX 用于培养基分配
03
克隆挑选
作为 QPix FLEX 最重要的一项功能,仪器配备了 2000 万像素的 CMOS 彩色相机,能对整个 9cm petri dish 进行全景成像。在菌落检测阶段,通过调节仪器的阈值及算法,可以识别到各种类型的克隆。通过进一步调节菌落形态学阈值,即可筛选出待挑选目标克隆(图 4),还可以针对个别克隆手动进行更改。另外,仪器还能根据参数对筛选到的克隆进行分组,并在接下来的的克隆挑取过程中对不同组别的克隆挑取数目进行设定。除此以外,研究人员可对克隆进行编号,并根据每个克隆所在的坐标及编号精确定位到任何一个克隆所在的位置(图 5)。
图 4:目标克隆的筛选(黄色为待挑克隆,红色为被排除的克隆)

图 5:克隆编号方便追踪
04
菌液培养
将接种克隆的 96 孔深孔板置于厌氧环境中 37℃ 培养 48h。
05
取菌液沉淀做基质辅助激光解吸电离飞行时间质谱
取步骤 4 部分菌液做 MALDI-TOF-MS 质谱分析,经比对,鉴定出菌种信息(图 6)。

图 6:MALDI-TOF-MS 鉴定菌种信息
06
菌液传代及保存
MALDI-TOF-MS 鉴定之后得到菌种信息,此时可根据结果将目标菌种的部分菌液转移到新的培养板中进行扩培,为下一步的菌种保存做准备。此时,利用 QPix FLEX 的菌液重排功能即可将目标菌种集中到同一块 96 孔深孔板(图 7)。将得到的菌液 37℃ 厌氧培养 48 后,与 50% 甘油混合后冻存。

图 7:QPix FLEX 的重排功能

本次测试证实了 QPix FLEX 能完成益生菌筛选过程的各个相关步骤,帮助科研人员解决益生菌筛选过程的诸多痛点,其中包括厌氧箱操作不便捷,因为人为因素导致的克隆挑取随机,密集生长的克隆难以挑取等。另外,QPix FLEX 还保留了包括涂布,移液,克隆挑取及复制重排过程的电子记录,能帮助科研人员追踪每一步的操作,其中还包括克隆在琼脂培养基的位置信息。这些都说明 QPix FLEX 是科研人员在益生菌筛选过程中的得力助手,全面助力益生菌开发。
参考文献
[1]. J. Gao et al., Probiotics in the dairy industry-Advances and opportunities. Compr Rev Food Sci Food Saf 20, 3937-3982 (2021).
[2]. M. Bermudez-Brito, J. Plaza-Diaz, S. Munoz-Quezada, C. Gomez-Llorente, A. Gil, Probiotic mechanisms of action. Ann Nutr Metab 61, 160-174 (2012).

QPix FLEX 微生物克隆筛选系统

关于美谷分子仪器
Molecular Devices 始创于上世纪 80 年代美国硅谷,并在全球设有多个代表处和子公司。2005 年,Molecular Devices 在上海设立了中国代表处,2010 年加入全球科学与技术的创新者丹纳赫集团,2011 年正式成立商务公司:美谷分子仪器 (上海) 有限公司。Molecular Devices 以持续创新、快速高效、高性能的产品及完善的售后服务著称业内,我们一直致力于为客户提供在生命科学研究、制药及生物治疗开发等领域蛋白和细胞生物学的创新性生物分析解决方案。





